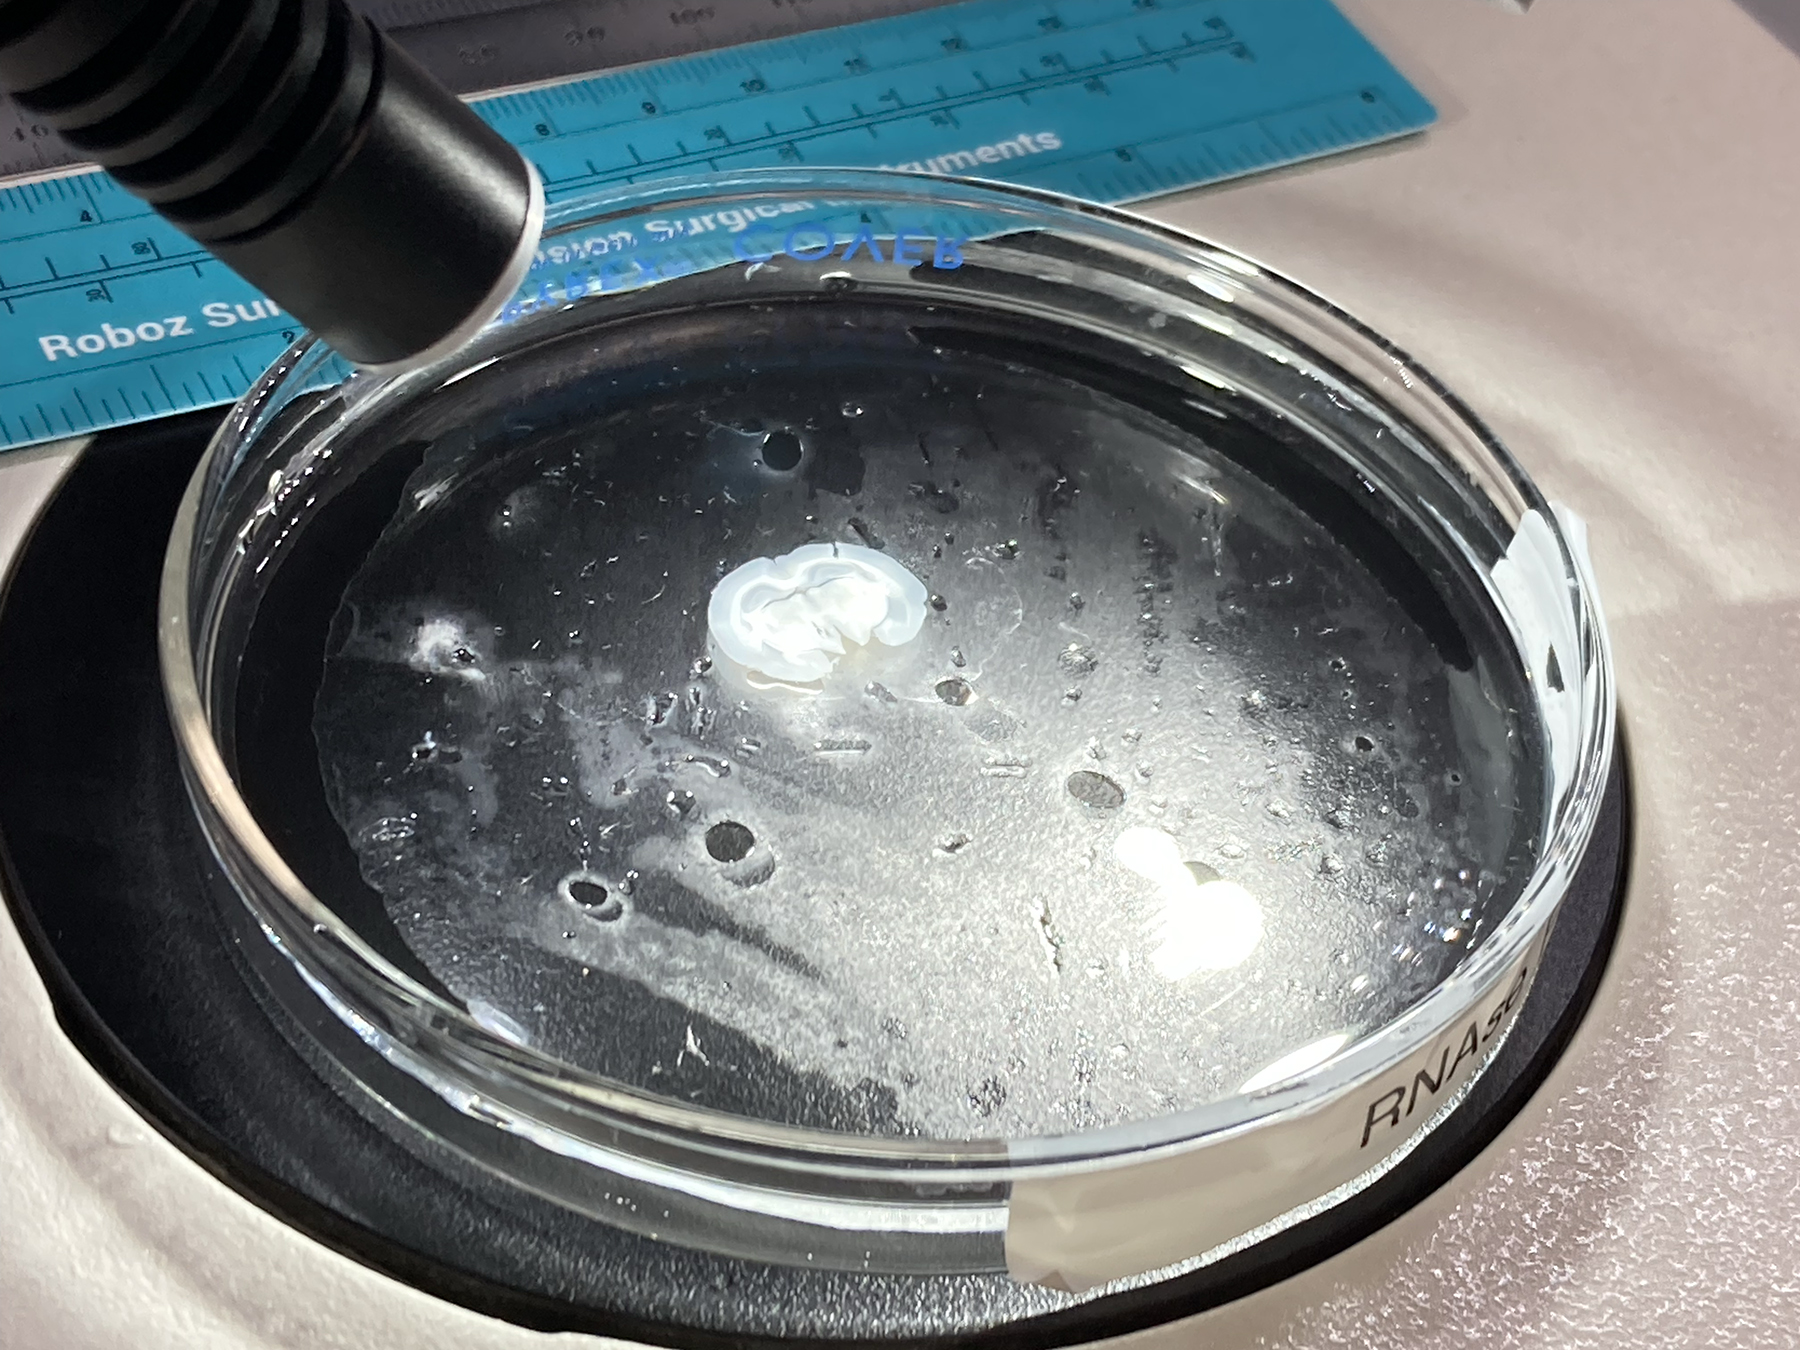

In my hands is a squirrel-sicle, or close to it. I’m standing in a walk-in fridge, bathed in red light, cradling a rigid, furry body nearly as cold as ice. The thirteen-lined ground squirrel is hibernating and deep in torpor. It feels surprisingly dense and hard as the chill seeps from the tiny mammal through a latex glove and to my palm.
In this state, I’m told the squirrels still breathe two or three times per minute, but despite squinting to catch the animal in my hand mid-inhalation, I cannot see its chest rise or fall. Rafael Dai Pra, a PhD candidate in his sixth year of studying hibernation, points out the occasional, involuntary micromovements of the squirrel’s leg–one of the only visible indicators it’s alive. “We think it’s some sort of spinal cord stimulus. You see the paw retracts,” Dai Pra says as he nudges it with a finger. The movement response is an oddity one of his colleagues, another graduate student Rebecca Greenberg, is studying. Dai Pra is investigating a separate marvel: How animals undergo sexual maturation in this deep state of metabolic and physiological depression.
Both graduate students are part of Elena Gracheva’s laboratory at Yale School of Medicine. The professor of cellular and molecular physiology and neuroscience leads a research group dedicated to unraveling the biological mechanisms that enable and regulate hibernation. It’s one of a handful of labs around the world keenly focused on hibernator physiology and what examining the extreme phenomenon can tell us about animals and enable for ourselves.

Through this work following the seasonal cycle of squirrels, scientists have their sights set on possibilities that can sound like science-fiction: improved organ transplantation, pharmaceutical treatments for anorexia, safer open heart surgery, stroke recovery, and even inducing hibernation-like states in people. If science were to discover a method for safely and reversibly tamping down humans’ metabolic rate for extended periods, the applications would be multifold. Such an intervention might even help astronauts reach deep space. It’s a lot of potential piled atop small, squirrel shoulders and the biologists dedicated to understanding them better.
Life on the brink
Picture a hibernating animal and you might imagine a slumbering bear, snores and Zzz’s emanating from its cozy den. But the reality is far beyond a snooze. It’s closer to death than sleep, Gracheva tells me during a conversation in her basement office. “It’s a state like suspended animation,” she says.
Animals enter torpor through sleep, and in a way sleep echoes the metabolic reductions of hibernation. In sleep, human metabolism drops by around 15% and our body temperatures also fall a few degrees. But hibernation is far more extreme and plays a different role. Hibernation is a survival strategy evolved out of deprivation, present in animals as disparate as frogs and lemurs. When resources dwindle and the world becomes inhospitable, hibernators retreat from life and wait it out. Ground squirrels’ metabolic rate crashes by as much as 90-95%, says Gracheva.
“It’s a state like suspended animation.”
During the hibernation season, which lasts between six and eight months for thirteen-lined ground squirrels, the animals do not eat or drink anything. In the wild, they’d remain in small underground burrows for the duration. In the lab’s hibernaculum, they see it through in plastic bins dubbed hibernation boxes. While hibernating, the squirrels spend the bulk of their time in torpor interspersed with brief bouts of activity called “interbout arousals.” These IBA periods last hours to a couple of days, with each round of torpor spanning two to three weeks.
In torpor, their body temperature plummets to below 40 degrees Fahrenheit and their pulse and respiration rate to just a few beats each minute. Brain activity becomes startlingly low. Electroencephalogram (EEG) read-outs of the neural waves “just look flat,” says Kelly Drew, a professor at the University of Alaska Fairbanks who began her scientific career as a neuropharmacologist and has become one of the world’s leading experts on mammalian hibernators. “It’s even less activity than a coma state,” she adds, agreeing that hibernating is more like dying than sleeping. “They’re just on the verge. They’re turning down the pilot light to where it’s right on the edge,” Drew says.

At Yale, the scientists have implanted each of their thirteen-lined ground squirrels with a temperature sensor to monitor the fluctuations of hibernation. When scanned with a digital wand, the squirrel I’m holding reads out at 27.1 degrees Fahrenheit, though I’m later assured that’s because the sensors lose accuracy at low temperatures. The rodent wasn’t actually colder than frozen. That would be impossible–only Arctic ground squirrels, the kind Drew studies in Alaska, can supercool. Their cousins in more temperate climes merely get near freezing, never below it.
Yet amazingly, during those brief IBA interruptions, the animals’ body temperature, circulation, and breathing return to active levels. Suddenly, the squirrels are revived (albeit still not ingesting any food or fluid). While in IBA, they’ll chitter, stretch, and move about their nests. They’ll also expel small amounts of metabolic waste and take frequent naps. Over the course of the hibernation season, ground squirrels will lose almost all of their accumulated body fat, and nearly all that loss happens during IBA. Each brief arousal leads to about 4g of weight loss in the thirteen-lined squirrels, says Ni Feng, a former post-doctoral researcher in Gracheva’s lab and now an assistant professor of biology at Wesleyan University where she’s begun her ownhibernation lab.
“It’s even less activity than a coma state… They’re just on the verge. They’re turning down the pilot light to where it’s right on the edge.”
“It’s not as if they’re just cold meat in the fridge for [eight] months. They are actually dynamically changing,” Feng says. Though clearly important, scientists aren’t exactly sure why these active periods occur, she notes. One idea is that it helps them retain organ and brain function in the long-term, giving their body’s neurophysiological circuitry a chance to remember its rhythms. Other theories include that the squirrels need IBA to have a chance to manufacture proteins and other cellular necessities, re-set their internal clocks, get rid of waste, burn fat to access stored water, or catch up on the sleep that they don’t get while in deep torpor. Potentially, she explains, multiple factors contribute.
“I think of a car that’s sitting idle in the winter. It doesn’t function very well if you let it sit for months. You have to restart it every other week to just make sure all systems are ok to go,” Feng says.
Back in the red-lit hibernaculum, I can hear scratching and scurrying emanating from some of the plastic bins. Whether or not science can explain it yet, the squirrels still have a schedule to stick to.

The true purpose of IBA is just one of the ongoing mysteries. Another is how animals keep track of time and what signals an animal to shift states. Some species, like Syrian hamsters, are facultative hibernators which enter hibernation in response to certain external conditions like reduced light exposure and cold temperatures. Ground squirrels, and a host of other mammals, however, hibernate no matter what their surroundings.
Full torpor is only enabled by cold, as animals can’t become colder than the ambient temperature (“they’re not refrigerators,” says Gracheva). But ground squirrels kept in a warm, brightly lit space all winter will still reduce their metabolic activity. They still eat and drink far less than their summer counterparts. “There is a strong component of seasonality and animals that still have resources [available to them in January] don’t look the same as active animals in June and July,” Gracheva notes.
Hoping to conduct a scientific symphony
Hibernation is an intricate physiological process with many components–systems have to shut down and reactivate in a coordinated fashion in response to internal and environmental cues. “We say it’s like an orchestra,” says Dai Pra. Through research, scientists are getting a sense of all of the players. By reverse engineering the orchestra, science may one day enable us to conduct the symphony–manipulating metabolism, body temperature, appetite, and activity in squirrels, but also humans.
In doing so, we might be able to take advantage of hibernation’s benefits for ourselves. There’s the obvious fact that hibernators conserve resources. If one were to travel somewhere months or years away, like a distant planet, then some sort of partial torpor would mean spaceships could carry far less burdensome water and food, economizing space and fuel. But that’s not the only upside.
Hibernating animals are remarkably good at preserving lean body mass. Though they lose fat, they hold on to most of their muscles, explains Dai Pra. Astronauts on long missions in microgravity have to exercise hours a day to try to do the same. If we understood how hibernators resist atrophy, perhaps we could help humans stay healthier in space.
“It’s not as if they’re just cold meat in the fridge for [eight] months. They are actually dynamically changing.”
Torpor also seems to have protective and regenerative effects for other bodily systems like the brain and heart. Some studies indicate that reduced body temperature lowers inflammation and helps heal traumatic brain injury, and is protective in the aftermath of strokes and cardiac arrest. Torpid animals also incur less damage from radiation, likely because their cells aren’t regenerating as quickly. Cosmic radiation poses a perennial challenge for astronaut safety, says Hannah Carey, an emeritus professor of biology at the University of Wisconsin-Madison, where she studied hibernators as a model for stress and trauma protection.
Carey has been part of meetings and conferences with ESA and NASA scientists discussing hibernation science. In these dialogues, she recalls that radiation protection has been of particular interest.
NASA and the European Space Agency have funded hibernation research for decades. The idea of ‘synthetic torpor’ for long-distance space travel first emerged in the 1960’s. Though there’s been ebbs and flows in investment since the heyday of the space race, renewed interest in reaching Mars and space-obsessed billionaires like Elon Musk and Jeff Bezos have recently reinvigorated funding for hibernation science. “Now there’s a resurgence going on,” says Carey. Drew, for instance, was awarded NASA Space Grant funds to continue her work on Arctic ground squirrels in 2023. The space agency also awarded biotech company Fauna Bio grant money to conduct hibernation research last January. Private aerospace companies like SpaceWorks have also supported hibernation science.
Yet it’s not just astronauts that might benefit from such research. Back on Earth, the possibility of human torpor also holds promise for medicine. Gracheva imagines potential drug interventions to encourage appetite in those with physiological anorexia (like the kind that is common in older adults or with chemotherapy). Her and Carey’s labs have both collaborated with researchers who work on organ transplantation–looking for better methods of preserving organs outside the body and of boosting outcomes of surgeries involving temporary, induced hypothermia.
Drew envisions applications for those with Alzheimer’s and other neurodegenerative diseases, reversing coma, and treating diabetes. (Ground squirrels become insulin intolerant in the lead-up to hibernation, as they gorge and gain weight. But then, that reverses.) Broadly, studying hibernation could unlock secrets to living longer and healthier, and avoiding age-related declines, says Drew.
Ground squirrels are remarkably long-lived for rodents of their size. Their lifespans are eight or nine years, compared with a rat’s two to three, notes Gracheva. Time spent in torpor is likely a big part of why. A 2022 study found that yellow bellied marmots, another obligate hibernator, age much more slowly during hibernation compared with the active season.
Unraveling squirrel secrets
In 2011, inspired by prior research in mice, Drew and colleagues published a study showing that stimulating or blocking adenosine receptors in the brain could induce or interrupt torpor in Arctic ground squirrels during winter. Since then, Drew’s lab has replicated promising results, using the method to lower body temperature in rats and pigs. The idea is that the right drug cocktail, stimulating the correct receptors in the nervous system without disrupting other organs, could trigger a torpor-adjacent state in humans. There’s still many open questions and roadblocks to reaching that ideal destination, but in recent years, scientists have made additional big strides in understanding the phenomenon and they’re far from giving up the quest.
“There are examples of hibernators in all mammalian clades and orders including [primates],” says Gracheva. This, Carey notes, means somewhere in the DNA of our ancestors, the path for hibernating was present. “I like to say the blueprint for hibernation is in the primate game plan. It’s somewhere in our bodies,” she says.
“I like to say the blueprint for hibernation is in the primate game plan. It’s somewhere in our bodies.”
In Gracheva’s lab, more than a dozen researchers pull at separate threads of the hibernation tangle, seeking to unravel the whole thing. Just this year, the Yale scientists published research revealing how hunger is regulated (and functionally eliminated) in hibernating squirrels. A deficiency of thyroid hormone in the hypothalamus explains it, per the study. If you dose a squirrel in IBA with thyroid hormone in the regulatory brain region, they start to eat.
Another study, co-led by Feng and published last February, outlined how the hormones vasopressin and oxytocin fluctuate to manage water conservation and fluid homeostasis during hibernation, when all standard logic would indicate squirrels must get severely dehydrated. Yet they don’t, thanks in part to anti-diuretic mechanisms that prevent water loss, according to the research. A follow-up study published last month in the journal Science found that a key brain region linked to thirst is suppressed in hibernating squirrels, even during IBA, preventing the animals from leaving the safety of their burrows to seek out water.

To come to these findings, Feng and her co-authors deployed fiber photometry–an imaging technique that uses fluorescent proteins to track calcium’s movement in the body, and thus neuron activity. Fiber photometry is often deployed in model organisms like mice and rats, whose genes can be manipulated. But here, the scientists were able to use a modified adenovirus to introduce the fluorescent calcium sensor–a first in an obligate hibernator. “It took us four years to develop the method,” Gracheva says, but the effort paid off.
In another few years, she imagines further technological advances and all the knowledge they’ve gained will enable them to label specific neural pathways in the squirrels through modified viruses. And perhaps one day soon they’ll know enough to do more than track and label the squirrels’ cells. Gene editing, she says, is on the horizon. If and when scientists can knock out individual genes and observe how that affects hibernation, they’ll be able to definitively home in on cause and effect.
“We’re on the cusp of a new era of access to molecular tools for [these] non-model organisms. Elena [Gracheva] has really been a pioneer in that,” Drew says.
Away from the hibernaculum and in the bright-white lab, I watch a graduate student carefully dissect a squirrel and extract a cross section of brain. She places the slice in a petri dish, to examine the squirrels’ neural response to signaling chemicals. I listen to Dai Pra describe his research on how testosterone levels rise towards the end of hibernation, and males come out of stasis ready to mate. Maryann Platt, a postdoctoral researcher, is nearby compiling data for a manuscript about how hibernators modify their blood brain barrier to avoid leakage and damage with the intense temperature fluctuations.
The squirrels may not have gotten us to distant stars yet, but with the dangling possibility propelling science forward, they’ve unlocked an entire universe of knowledge.